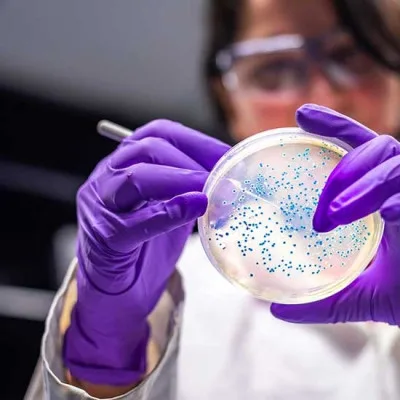
Rasanya Juara, Tapi Amankah? Pentingnya Analisis Mikrobiologi untuk Keamanan Pangan

Komentar 0
Rasanya Juara, Tapi Amankah? Pentingnya Analisis Mikrobiologi untuk Keamanan Pangan
DISTRIKBANTENNEWS.COM - Pentingnya keamanan pangan Makanan dan jajanan yang lezat tentu selalu menggoda selera, namun rasa saja tidak cukup tanpa jaminan keaman...
Kembali ke artikel...Berikan Opinimu
Isi komentar sepenuhnya adalah tanggung jawab pengguna dan diatur dalam UU ITE
0 Komentar